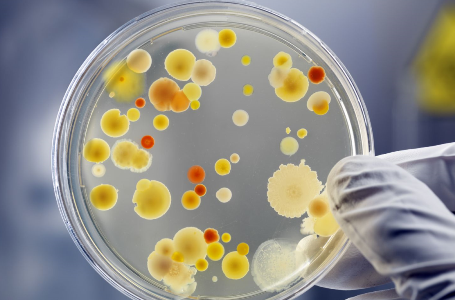

Sa discutam despre cancerul de col uterin cu medicul oncolog Dr. Adela Chirila

Doresc sa aflu mai multe detalii
Conform Centrului National de Evaluare si Promovare a Starii de Sanatate, desi cancerul de col uterin este forma de cancer cea mai usor de prevenit, in Romania ne confruntam cu cele mai inalte rate de incidenta si mortalitate din Europa. In 2012 in Romania se inregistrau 4343 cazuri noi de cancer de col uterin, adica o incidenta de 3,5 ori mai mare decat media Uniunii Europene. Romania inregistra cele mai inalte valori ale incidentei si mortalitatii prin cancer de col uterin (34 respectiv 14/100 000) fata de media UE (10 respectiv 4/100 000). Cancerul de col uterin era al doilea tip ca incidenta, dupa cel mamar, si reprezenta principala cauza de mortalitate la femeile cu varsta intre 15 si 44 de ani.
Care sunt cauzele de aparitie a cancerului de col uterin?
Principala cauza a cancerului de col uterin (cervical) o reprezinta infectia persistenta cu virusul uman Papilloma (HPV). Practic, aproape toate cazurile de cancer de col uterin sunt cauzate de HPV, acesta fiind detectat in 99% din tumorile cervicale. Debutul precoce al vietii sexuale, numarul mare al partenerilor sexuali, fumatul, imunosupresia, co-infectia cu alti agenti infectiosi cu transmitere sexuala (gonoree, herpes simplex, chlamydia), numarul de nasteri si varsta tanara la prima nastere sunt, de fapt, factorii favorizanti pentru infectia persistenta cu HPV.
Ce este mai exact acest HPV?
HPV este un grup de virusuri (peste 100), iar dintre aceste tulpini, cel putin 14 cauzeaza cancer. Aceste tulpini au fost incluse in Grupa 1 de agenti carcinogenetici pentru organismul uman.
Dintre aceste tulpini, HPV 16 si 18 sunt responsabile de 70% din cancerele cervicale si leziunile cervicale pre-canceroase. Infectia cu anumite tulpini HPV de risc inalt provoaca si alte tipuri de cancer: anal, vaginal, vulvar, orofaringian si penian.
Cum apare infectia cu HPV?
HPV este o infectie cu transmitere predominant prin contact sexual, extrem de contagioasa. Majoritatea oamenilor de pe planeta sunt infectati cu HPV la scurt timp dupa debutul vietii sexuale. In majoritatea bolilor cu transmitere sexuala, folosirea corecta si consecventa a prezervativelor este extrem de eficienta. Din pacate, cand vorbim de HPV, prezervativele au o eficienta partiala in prevenirea infectiei si implicit a bolilor asociate cu HPV (cancerul cervical si condiloamele genitale), dar pot reduce riscul. HPV se transmite prin contact cu pielea infectata de la nivel genital sau cu suprafete mucoase si secretii.
Toate persoanele infectate cu aceste tulpini carcinogenetice fac cancer?
Evident ca nu! Aproximativ 80% din infectii sunt autolimitante. Asta inseamna ca se vindeca de la sine. In momentul in care sistemul imunitar nu reuseste sa elimine acest virus si infectia devine persistenta, atunci apar leziunile precanceroase care, fara interventie, evolueaza malign.
Ce este de facut impotriva HPV?
In lupta impotriva HPV este importanta PREVENTIA! Cum putem face asta? Prin vaccinare! Pe piata exista actualmente 3 vaccinuri: bi-, tetra- si nona- valent. Toate sunt eficiente impotriva tulpinilor HPV 16 si 18. Ultimele 2 protejaza si impotriva infectiei cu HPV 6 si 11, responsabile de aparitia verucilor anogenitale.
vaccinare! Pe piata exista actualmente 3 vaccinuri: bi-, tetra- si nona- valent. Toate sunt eficiente impotriva tulpinilor HPV 16 si 18. Ultimele 2 protejaza si impotriva infectiei cu HPV 6 si 11, responsabile de aparitia verucilor anogenitale.
Vaccinarea HPV are impact major asupra cancerului cervical si a celorlalte tipuri de cancere asociate HPV, atat la femei cat si la barbati. De exemplu, vaccinarea are ca efect reducerea anuala cu 90% a cazurilor de cancer cervical si cu 85% a cazurilor de cancer penian asociate HPV.
Testele recomandate pentru femeile cu varsta cuprinsa intre 25-65 de ani: testarea citologica Babes-Papanicolau (PAP) clasica sau citologia in mediu lichid si testarea ADN HPV pentru depistarea tipurilor cu risc inalt. Laboratorul Gral Medical de Biologie Moleculara ofera pachete speciale pentru scrrening-ul cancerului de col uterin: Gynaika HOPS (Cobas HPV + PAP in mediu lichid), Gynaika HOPS PLUS (HPV Genotipare, 37 tulpini + PAP in mediu lichid) si Gynaika H-CIN (Cobas HPV + CINtec Plus).
Important!
Trebuie sa retinem: cancerul cervical (de col uterin) este una din formele cele mai usor de prevenit si de vindecat forme de cancer, atata timp cat este detectat la timp si abordat eficient. Este un tip de cancer care are nevoie de 15-20 de ani pentru a se dezvolta la o femeie cu sistem imunitar NORMAL!
Dr. Adela CHIRILA, medic specialist oncologie medicala, ofera consultatii de specialitate la Spitalul OncoFort Pitesti de luni pana miercuri, in intervalul orar 11:00 – 15:00.
Serviciile medicale oncologice (chimioterapia si medicamentele) sunt decontate 100% de CNAS.
Pentru programari la medicul oncolog puteti suna la Call center: 0348-410.201 sau direct folosind formularul de programari de mai jos.


 Solicita programare
Solicita programare

